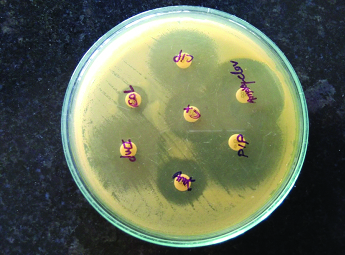

Pyogenic Liver Abscess Caused by Acinetobacter lwoffii: A Case Report
N. Pal Singh1, Tanu Sagar2, Kirti Nirmal3, I. Rajender Kaur4
1 Professor, Department of Microbiology, University College of Medical Sciences and Guru Tag Bahadur Hospital, East Delhi, India.
2 Senior Resident, Department of Microbiology, University College of Medical Sciences and Guru Tag Bahadur Hospital, East Delhi, India.
3 Post Graduate Student, Department of Microbiology, University College of Medical, Sciences and Guru Tag Bahadur, Hospital, East Delhi, India.
4 Professor and Head, Department of Microbiology, University College of Medical Sciences and Guru Tag Bahadur Hospital, East Delhi, India.
NAME, ADDRESS, E-MAIL ID OF THE CORRESPONDING AUTHOR: Dr. Tanu Sagar, Senior Resident, Department of Microbiology University College of Medical, Sciences and Guru Tag Bahadur, Hospital Delhi-110095, India.
E-mail: tanu.sagar18@gmail.com
Acinetobacter lwoffii is a gram negative aerobic non-fermenter bacilli. It is considered as an important emerging pathogen after Acinetobacter baumannii in patients with impaired immune system and in nosocomial infections. Here, we present a case of community acquired pyogenic liver Abscess caused by Acinetobacter lwoffii in a diabetic patient.
Ciprofloxacin, Diabetic, Non-fermenters
Case Report
A 42-year-old man, presented to the Medicine Department of our hospital with the complaint of high grade fever, vomiting, yellowish discoloration of sclera, abdominal distension and weakness since last one week. Patient also gave history of pain in abdomen which was usually located in the right hypochondrium and abdominal discomfort since last one month. There was a history of diabetes mellitus type- 2 since last two years; he was on anti-hyperglycaemic medication irregularly. No history of tuberculosis or similar episode in the past and no relevant family history were present. On examination he was conscious, febrile (Temperature-39°C), pulse rate 98/min and blood pressure were 110/88 mmHg. He had pallor and icterus. As per abdominal examination patient had distended abdomen, tenderness in right hypochondrium and epigastrium regions, umbilicus inverted, nodulated vein were seen, itching marks present on lower abdomen and free fluid present, but, abdomen thrill were absent. There was tender hepatomegaly 4cm below the costal margin, but spleen was not palpable. Rest of systemic examination was within normal limit. Laboratory haematological investigation revealed hemoglobin 8.5gm/dl, total leukocytes count 6100/cumm, (polymorphs 74 %, lymphocytes 24%, eosinophil 2 %), Platelets count of 1.5 lacs/cumm, however liver enzymes (SGOT/SGPT-92/65), coagulation profile (PT/PTTK-12.6/27.0) and Alkaline phosphatase were elevated to 958 IU. Renal function and serum electrolytes were within references range.
Serology for Hepatitis B surface antigen (HBSAg- 7.38 IU/L) was also elevated from the normal reference range. While, serology from HIV and other hepatitis markers (HCV) were non-reactive. Widal test and IgM leptospira were also negative. Ultrasonography of the abdomen showed enlargement of the liver with features suggestive of abscess measuring 8cm×8cm×8.6cm and volume 700CC involving segment VI and VII along with mild ascites. Ultrasound guided liver aspiration was done. About 30ml of pus was aspirated and sent for microbiological investigations, for culture and sensitivity. The pus sample received was processed as per standard microbiological protocol. A wet mount of pus was negative for Trophozoites of Entamoeba histolytica. Ziehl–Nelsen was negative for acid fast bacilli. Direct Gram’s stain showed gram negative bacilli along with the pus cells [Table/Fig-1]. Haemolytic colonies of 2–3mm diameter grew on blood agar and non-lactose fermenting colonies on Mac-Conkey agar. The isolate was identified as A.lwoffii on the basis of biochemical reactions with cytochrome oxidase (negative), oxidative/fermentative glucose (negative), nitrate reduction (negative), and citrate (negative). It was confirmed by automated technique with Vitek-2 system. It was found to be susceptible for cefotaxime, amikacin, ciprofloxacin, imipenem, piperacillin-tazobactam amoxy-clavulanic acid & colistin by Kirby Bauer disc diffusion method [1] [Table/Fig-2]. Skin swab and blood sample were sterile even after 48 hours. However stool sample revealed the growth A. lwoffii with the antibiotic pattern compatible with the isolate from liver abscess. A repeat sample was asked after 48 hours which showed the growth of same organism.
Discussion
Pyogenic Liver Abscess (PLA) is a life threatening disease if left untreated and data from different sources place the incidence rate from 1.1 to 17.6/1,00,000 individuals [2]. The most common pathogens associated with PLA are Escherichia coli, Klebsiella pneumoniae, Bacteroides, Enterococci, Streptococci, and Staphylococci [3]. Here we presented a case of PLA caused by A. lwoffii which is the first case as per our extensive research. Acinetobacter species were considered as low pathogen during 1960s but with the introduction of powerful new antibiotics in clinical practice and agriculture and the use of invasive procedures in hospital intensive care units (ICUs), drug resistant-related community and hospital-acquired Acinetobacter infections have emerged with increasing frequency [4]. Among its species, A. baumannii has emerged as of a greatest clinical importance and is associated with hospital outbreaks. But infections due to other species like A. lwoffii have also been reported in hospitals and community settings [5,6]. A. lwoffii, formerly known as Mima polymorpha or Acinetobacter calcoaceticus var. lwoffii is a non-fermentative aerobic gram-negative bacillus and it is known that 25% of the healthy individuals harbor as a commensel in oropharynx and skin. Infection results if the host first line of defense is compromised. Due to its ubiquitous nature, it is a potential opportunistic pathogen in individuals with impaired immune systems, and it has been identified as a cause of nosocomial and community acquired infections like septicaemia, bacteraemia, bacteriuria, pneumonia and endocarditis [Table/Fig-3].
Gram stain of pus in liver Abscess.

Antibiotic susceptibility profile of the A.lwoffi
Cip – ciprofloxacin CX – cefotaxime AMK – amikacin Impenem
AMC – amoxyclavulanic acid PIP – Piperacillin-tazobactam
Infections found to be associated with Acinetobacter Lwoffii.
| Authors | Patient’s profile | Disease / Condition | Country | Year |
|---|
| Mittal et al., [5] | Neonates | Septicaemia | India | 2015 |
| Silva et al., [6] | 28 months female | Community acquired pneumonia | portugal | 2012 |
| Tyoshima et al., [7] | 63 y / male | Fulminant pneumonia | Japan | 2010 |
| Regalado et al., [8] | 64 y / male | Bacteraemia followed by gastero-enteritis | Texas USA | 2009 |
| Nakwan N et al., [9] | Neonates | Septicaemia, pneumonia | Thailand | 2011 |
| Ahmadi et al., [10] | 63 y / male | Left sided Endocarditis | Iran | 2009 |
| Tega et al., [11] | Immunocompromized individuals | Catheter related bacteraemia | Italy | 2007 |
Some rare cases of community acquired infections like pneumonia and bacteraemia caused by Acinetobacter species have also been reported. A case of community acquired pneumonia cause by A. lwoffi in a child was reported from Portugal where the source of infection was not established but it was hypothesized to occur due to inappropriate use and poor sterilization of nebulizers [6]. Similarly in Japan Tyoshima et al., reported a fuliminant case of community acquired pneumonia in 63-year-old man where A. lwofii was reported as the probable cause [7]. In this, the patient succumbed to death in spite of the treatment. Regalodo et al.,, reported the case of community acquired A. lwoffi bacteraemia associated with gastroenteritis. Here frozen food was assumed to be the cause of gastroenteritis which lead to bacteraemia later on [8].
These case reports signify that A. lwoffii is also emerging as a important pathogen in hospital and communities.
In our case patient was diabetic for last 2 years and was on irregular anti- hyperglycaemic drugs along with the raised HBsAg. Direct gram’s stain showed gram negative bacteria along with the pus cells. His stool culture also showed the growth of A. lwoffi which had the same sensitivity pattern. So we presumed our patient to be a colonizer of A. lwoffii in gastrointestinal tract. It has been known that variety of food stuff including frozen chicken carcasses and milk products harbor Acinetobacter species with predominant species being A. lwoffi and A. johnsanii [12]. Moreover A. lwoffi tends to survive in dry conditions and in wide range of temperature and are resistant to used disinfection, irradiation and dessication [12]. These conditions may lead to colonization of the stomach by Acinetobacter spp. in the hyochlorhydric or achlorydric stomach [12]. We presumed our patient to be the colonizer of A. lwoffii which he acquired through ingestion of food contaminated with A. lwoffi. Weak immune status of the patient because of diabetes and virulence potential of the pathogen may have been the factors which lead to the spread of the bacteria to liver from intestine via a portal system and eventually in the formation of liver Abscess.
Our strain was found to be pan sensitive but many studies have reported the high rates of antibiotic resistance in Acinetobacter species. Nakwen et al., showed good susceptible to netilmycin, imipenem, cefoperazone/sulbactam, while resistance to amikacin, gentamycin, ceftazidime, ceftriaxone, cefepime, and ciprofloxacin, clindamycin in neonatal septicaemia [9]. Mittal et al., reported high resistant to imipenem (57%), cotrimoxazole (57%), gentamycin (82%), piperacillin + tazobactum (61%) in A. lwofii as compared to other non-baumanii acinetobacter spp in nosocomial infections [5].
Acinetobacter species has been known to produce variety of beta – lactamases which confer resistance to aminopenicillins, ureidopenicillins, narrow-spectrum and expanded-spectrum cephalosporin, cephamycins. Partial susceptibility is retained for some relatively new antibiotics such as broad-spectrum cephalosporin (cefotaxime, ceftazidime, and cefepime), tobramycin, imipenem, amikacin, and fluoroquinolones [11]. Since our patient did not recall any previous history of hospital stay or prolonged antibiotic intake and our strain was pan sensitive so we presumed it to be community acquired infection through ingestion of food contaminated with A.lwoffii.
Conclusion
This is the first case report of community acquired liver abscess caused by A. lwoffii as it was sensitive to variety of commonly used antibiotics. Apart from A. baumananii other species are also emerging in hospital and community settings. Though Multi – Drug resistance till now is reported in hospital strains but measures are needed to be taken to prevent the emergence of resistance in other species.
[1]. Clinical and Laboratory Standards Institute (CLSI) 24th Informational Supplement, M100-S24. CLSI; Wayne, PA: 2014. Performance standards for antimicrobial susceptibility testing [Google Scholar]
[2]. Tian LT, Yao K, Zhang XY, Zhang ZD, Liang YJ, Y in DL, Liver Abscess in adult patients with and without diabetes mellitus: An analysis of the clinical characteristics, features of the causative pathogens, outcomes and predictors of fatality: A report based on a large population, retrospective study in ChinaClin Microbiol Infect 2012 18:314-30. [Google Scholar]
[3]. Meddings L, Myers RP, Hubbard J, Shaheen AA, Laupland KB, Dixon E, A population-based study of pyogenic liver Abscess in the United States: Incidence, mortality, and temporal trendsAm J Gastroenterol 2010 105:117-24. [Google Scholar]
[4]. Guardabassi L, Dalsgaard A, Olsen JE, Phenotypic characterization and antibiotic resistance of Acinetobacter spp. isolated from aquatic sourcesJ Appl Microbiol 1999 87:659-67. [Google Scholar]
[5]. Mittal S, Sharma M, Yadav A, Bala k, Chaudhary U, Acinetobacter lwoffii. An emerging pathogen in neonatal ICUInfectious Disorders – Drug Targets 2015 15:184-88. [Google Scholar]
[6]. Silva GM, Morais L, Marques L, Senra V, Acinetobacter community-acquired pneumonia in a healthy childRev Port Pneumol 2012 18:96-98. [Google Scholar]
[7]. Toyoshima M, Chida K, Suda T, Fulminant community-acquired pneumonia probably caused by Acinetobacter lwoffiiRespirology 2010 15:860-68. [Google Scholar]
[8]. Regaldo NG, Martin G, Antony SJ, Acinetobacter lwoffii: Bacteraemia associated with acute gastroenteritisTravel Medicine and Infectious Disease 2009 7:316-17. [Google Scholar]
[9]. Nakwan N, Warnaco J, Nakwan N, Multidrug-resistant Acinetobacter lwoffii infection in neonatal intensive care unitsRes Rep Neonatal 2011 1:1-4. [Google Scholar]
[10]. Ahmadi H, Boroumand MA, Anvari MS, Karimi A, Moshtaghi N, Left-Sided Endocarditis Associated with Multi-Drug Resistance Acinetobacter LwoffiiJ Teh Univ Heart Ctr 2009 3:189-92. [Google Scholar]
[11]. Tega L, Raieta K, Ottaviani D, Russo G, Blanco G, Carraturo A, Catheter-related Bacteraemia and Multidrug-resistant Acinetobacter lwoffiiEmerg Infect Dis 2007 13(2):355-56. [Google Scholar]
[12]. Rathinavelu S, Zavros Y, Merchant JL, Acinetobacter lwoffii infection and gastritisMicrobes Infection 2003 5:651-57. [Google Scholar]